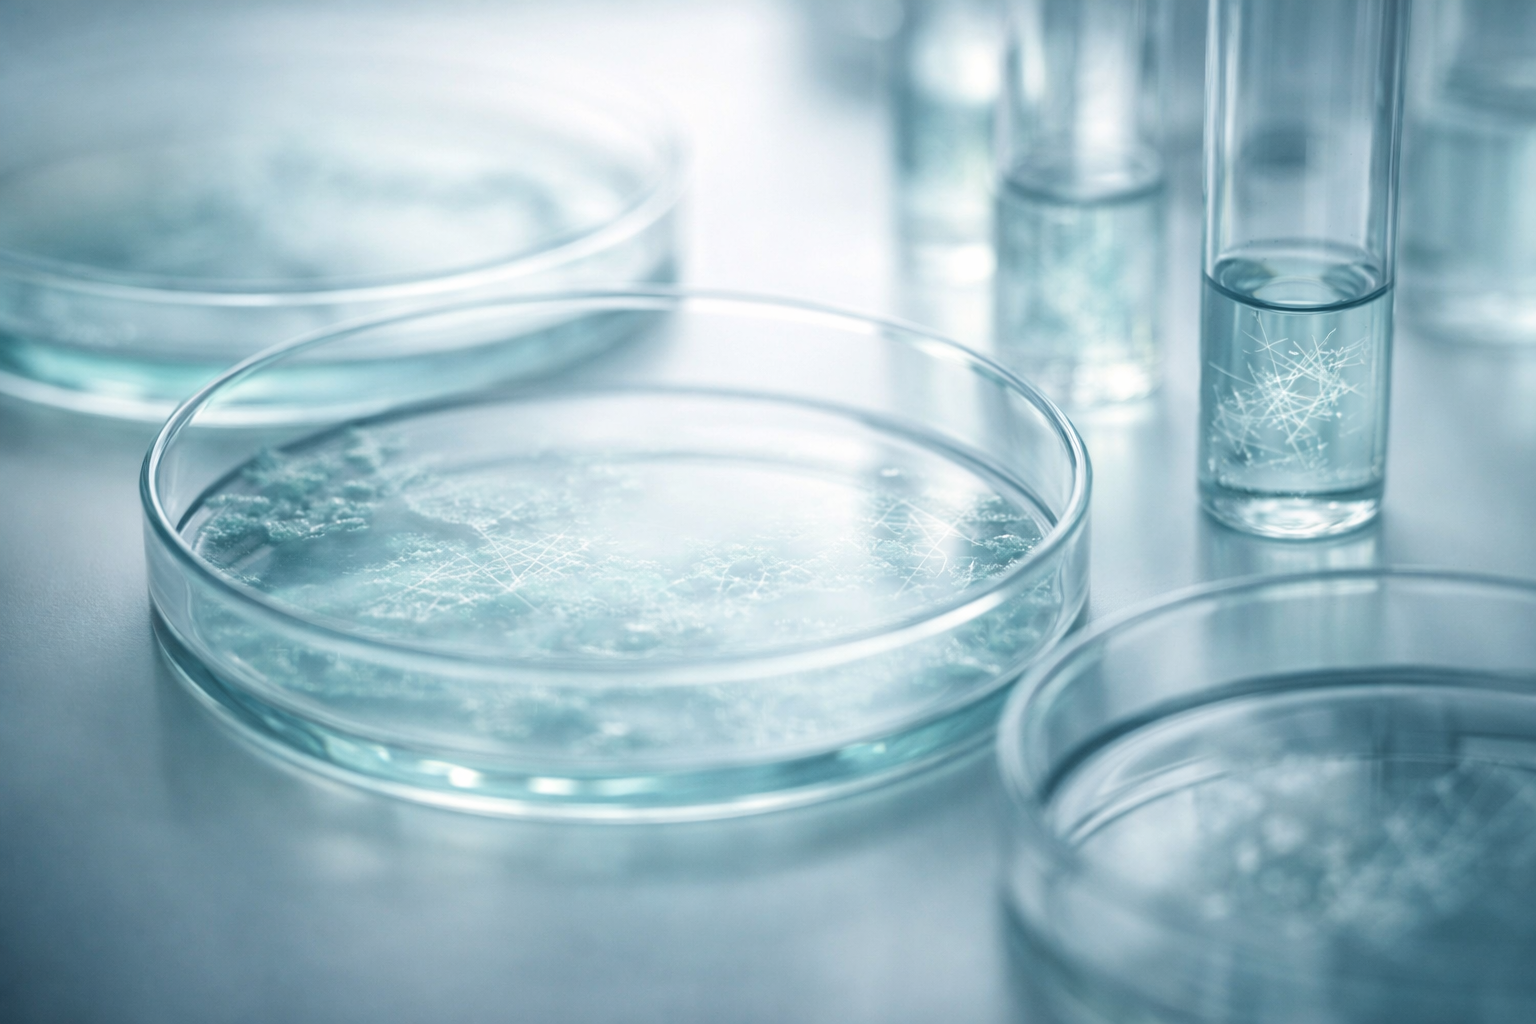
Healthcare & Life Sciences

We specialize in environments where failure is expensive. Our patterns are hardened in Energy, Industry, Banking, Insurance, and Life Sciences—bringing principal-level rigour to your specific regulatory and operational reality.

We help energy majors and grid operators move from isolated pilots to industrial-grade AI. Our focus is on safety-critical reliability, MLOps for forecasting, and governance for high-risk assets.
100+ use cases supported on unified platform

For organizations where IP protection is paramount. We design air-gapped or zero-trust GenAI architectures that allow engineers to access knowledge safely without leakage.
Secure RAG deployed to 5,000+ engineers

For Tier-1 banks and fintechs, we address the dual challenge of modernization and control. We design architectures that satisfy strict compliance requirements while enabling innovation.
Critical gaps identified in platform transformation

We help insurers rationalize scattered AI portfolios and focus on high-yield automation. Our work aligns technical capability with business strategy.
Focused investment on high-impact initiatives
For biopharma majors and medical device manufacturers. We address the unique overhead of clinical validation and R&D safety, building the governance layers required to scale AI in highly regulated life science environments.
Verifiable safety gates for medical devices
Our core capability is complex, regulated, and high-scale systems. If you deal with sensitive data, regulatory pressure, or mission-critical reliability, we speak your language.
Book a Consultation